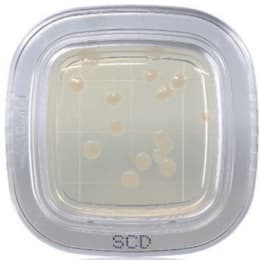

平片®DD 20片MLCB琼脂培养基PD0015 20片入
2023年08月29日 作者 fendu 370 0Petancheck®DD20张MLCB琼脂培养基PD0015 20枚,,厂家品号,PD0015,2022年度1562页,品名MLCB琼脂培养基,沙门氏菌检测用,PD0015,关联商品代码商品名0120804744平切®DD20枚琼脂培养基PD0001 20入3,200 0120804745平切®DD20枚去氧编码培养基PD00003 20入3,200 0120804746平切®DD20枚MSEY琼脂培养基PD0009 20枚入3,200 0120804747平检®DD20枚...